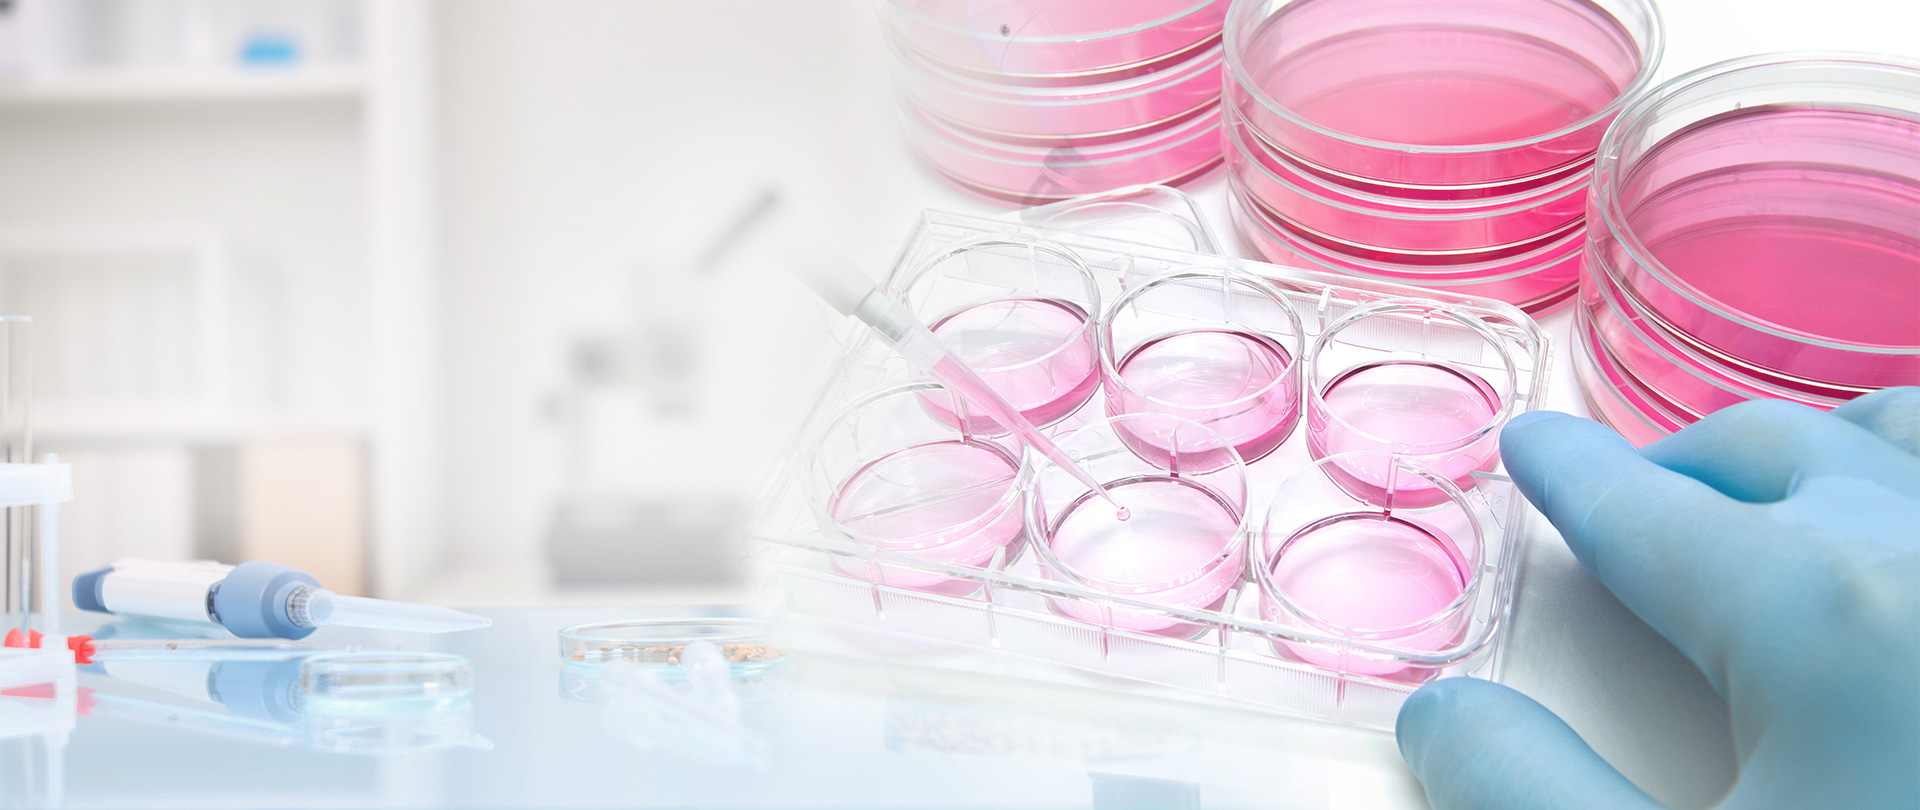
CMC Pharmaceutical Development

Rely on BOC Sciences to keep your lab operating at peak performance
BOC Sciences is a biological high-tech enterprise focusing on providing comprehensive Pharmaceutical and CMC Development services for all drug types including small molecules and biologics.
Start Getting More Done >-
Project Support Services
01BOC Sciences' global regulatory affairs service teams communicate and interact closely with our clients, fully understand their needs and requirements, and develop corresponding CMC filing strategies
-
Biologics
02BOC Sciences offers comprehensive services of biologic drug evaluation, and guides you every step of the way with our end-to-end cGMP analytical services and precise solutions.
-
Small Molecule
03Our broad portfolio of Small Molecule CMC services spans API development, manufacturing, drug product analysis, delivery and supply
Our Expertise
BOC Sciences is a trusted partner to the world's most innovative biotechnology and leading pharmaceutical companies.
We provide comprehensive small molecule drugs and biopharmaceutical services from pre-clinical development to full commercial production. Widely recognized for our expertise in complex chemistry and our dedicated customer experience.
Lear More About Us >Our Advantages
BOC Sciences is a trusted partner to the world's most innovative biotechnology and leading pharmaceutical companies.
-
10000+
Completed Cases
-
100+
Quality Services
-
99%+
Satisfaction Rate
-
7/24
Online Service
-
Facilities
R&D laboratories for analytical development and cGMP manufacturing
-
Flexible CMC
Extensive expertise and vertically integrated services to rapidly execute multiple projects
-
Compliance
Full process and product compliance at all stages of pharmaceutical development
-
Environmental, Health and Safety
A sound environmental, health and safety (EHS) management system
Interested in our services?
Contact us today to set up an appointment.